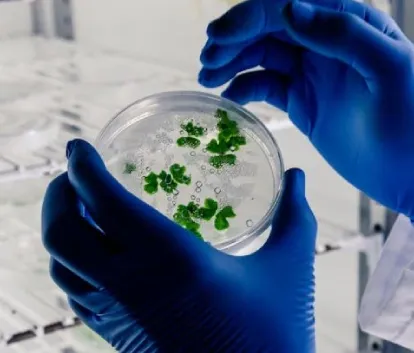
Integrated M.Tech In Biotechnology

The department offers five years Integrated MTech program with additional specialized core and elective courses with Biomolecules and Cell Communication, Nanobiotechnology, Phyto-therapeutics and Pharmacology, Regulatory Affairs, Drug Delivery, Genomics & Society Biostatistics, Product Development in Biotechnology, Experimental models in Research and Molecular Diagnostics. The curriculum is designed to generate trained manpower in biotechnology, equipping our students with knowledge and hands-on skills in constantly advancing biotechnological areas. Firm with our belief in comprehensive growth of our students, we work to enhance their proficiencies by our strategically designed laboratory experiments and mandatory components of Project Based Learning, Seminar & Term Papers along with year-long research project(s) and industrial trainings, providing the students with necessary scientific and professional exposure to firm their grounds before stepping in to their respective career directions, be it fields of R&D, academics, consulting, etc.
| Sr. No. | Course Code | Course Title | Course Category | L | T | P | Total | Credits |
|---|---|---|---|---|---|---|---|---|
| 1 | 15B11MA112 | Basic Mathematics-I | BSC | 3 | 1 | 0 | 4 | 4 |
| 2 | 15B11PH112 | Physics for Biotechnology | BSC | 3 | 1 | 0 | 4 | 4 |
| 3 | 18B11CI111 | Fundamentals of Computers & Programming - I | ESC | 3 | 1 | 0 | 4 | 4 |
| 4 | 15B11HS112 | English | HSC | 1 | 0 | 2 | 3 | 2 |
| 5 | 15B17PH171 | Physics Lab-1 | BSC | 0 | 0 | 2 | 2 | 1 |
| 6 | 24B45CS111 | Fundamentals of Computers & Programming Lab-1 | ESC | 0 | 0 | 2 | 2 | 1 |
| 7 | 18B15GE112 | Workshop | ESC | 0 | 0 | 3 | 3 | 1.5 |
| 8 | 24B11EC112 | Basic Electronics for Biotechnology | ESC | 3 | 1 | 0 | 4 | 4 |
| 9 | 24B15EC112 | Basic Electronics for Biotechnology Lab | ESC | 0 | 0 | 2 | 2 | 1 |
| TOTAL | 28 | 22.5 | ||||||
| Sr. No. | Course Code | Course Title | Course Category | L | T | P | Total | Credits |
|---|---|---|---|---|---|---|---|---|
| 1 | 15B11MA212 | Basic Mathematics-2 | BSC | 3 | 1 | 0 | 4 | 4 |
| 2 | 15B11PH212 | Biophysical Techniques | BSC | 3 | 1 | 0 | 4 | 4 |
| 3 | 18B11CI211 | Fundamentals of Computers & Programming - II | ESC | 3 | 1 | 0 | 4 | 4 |
| 4 | 18B15BT111 | Basic Bioscience Lab | BSC | 0 | 0 | 2 | 2 | 1 |
| 5 | 18B15CI211 | Computer Programming Lab-II | ESC | 0 | 0 | 2 | 2 | 1 |
| 6 | 24B16HS111 | Life Skills & Professional Communication Lab | HSC | 0 | 0 | 2 | 2 | Qualifying |
| 7 | 18B15GE111 | Engineering Drawing & Design | ESC | 0 | 0 | 3 | 3 | 1.5 |
| 8 | 24B11HS111 | Universal Human Values (UHV) | HSC | 2 | 1 | 0 | 3 | 3 |
| TOTAL | 24 | 18.5 | ||||||
| Sr. No. | Course Code | Course Title | Course Category | L | T | P | Total | Credits |
|---|---|---|---|---|---|---|---|---|
| 1. | 15B11MA302 | Probability and Statistics | BSC | 3 | 1 | 0 | 4 | 4 |
| 2. | 15B11BT211 | Biochemistry | PCC | 3 | 1 | 0 | 4 | 4 |
| 3. | 15B11BT311 | Thermodynamics and Chemical Processes | PCC | 3 | 1 | 0 | 4 | 4 |
| 4. | 15B11BT313 | Genetics and Developmental Biology | PCC | 3 | 1 | 0 | 4 | 4 |
| 5. | 15B17BT271 | Biochemical Techniques Lab | PCC | 0 | 0 | 2 | 2 | 1 |
| 6. | 15B17BT371 | Thermodynamics and Chemical Processes Lab | PCC | 0 | 0 | 2 | 2 | 1 |
| 7. | 15B17BT373 | Genetics and Developmental Biology Lab | PCC | 0 | 0 | 2 | 2 | 1 |
| 8. | 15B11HS211 | Economics | HSC | 2 | 1 | 0 | 3 | 3 |
| 9. | 24B17BT211 | Summer Training I (4 weeks) | PRC | 0 | 0 | 0 | 0 | 2 |
| 10. | 19B13BT211 | Environmental Studies | OMC | 3 | 0 | 0 | 3 | Qualifying |
| TOTAL | 28 | 24 | ||||||
| Sr. No. | Course Code | Course Title | Course Category | L | T | P | Total | Credits |
|---|---|---|---|---|---|---|---|---|
| 1. | XXXXXXX | HSS Elective -1 | HSC | 2 | 1 | 0 | 3 | 3 |
| 2. | 24B11BT211 | Molecular Biology | PCC | 3 | 1 | 0 | 4 | 4 |
| 3. | 15B11BT411 | Introduction to Bioinformatics | PCC | 3 | 1 | 0 | 4 | 4 |
| 4. | 15B11BT312 | Microbiology | PCC | 3 | 1 | 0 | 4 | 4 |
| 5. | 15B11BT414 | Immunology | PCC | 3 | 0 | 0 | 3 | 3 |
| 6. | 15B17BT372 | Microbiology Lab | PCC | 0 | 0 | 2 | 2 | 1 |
| 7. | 15B17BT471 | Bioinformatics Lab | PCC | 0 | 0 | 2 | 2 | 1 |
| 8. | 15B17BT474 | Immunology Lab | PCC | 0 | 0 | 2 | 2 | 1 |
| 9. | XXXXXXX | Discipline Elective-1* | PEC | 3 | 0 | 0/4 | 3/4 | 3 |
| TOTAL | 27 | 24 | ||||||
| Sr. No. | Course Code | Course Title | Course Category | L | T | P | Total | Credits |
|---|---|---|---|---|---|---|---|---|
| 1. | 24B11BT311 | Genetic Engineering | PCC | 3 | 1 | 0 | 4 | 4 |
| 2. | 24B11BT311 | Bioprocess Engineering | PCC | 3 | 1 | 0 | 4 | 4 |
| 3. | 24B15BT311 | Genetic Engineering Lab | PCC | 0 | 0 | 2 | 2 | 1 |
| 4. | 18B15BT311 | Industrial Biotechnology Lab-1 | PCC | 0 | 0 | 2 | 2 | 1 |
| 5. | XXXXXXX | Discipline Elective -2* | PEC | 3/2 | 0 | 0/2 | 3/4 | 3 |
| 6. | XXXXXXX | Discipline Elective -3* | PEC | 3/2 | 0 | 0/2 | 3/4 | 3 |
| 7. | 18B12HS311 | Science Elective | BSC | 3 | 0 | 0 | 3 | 3 |
| 8. | 18B12HS311 | Indian Constitution & Traditional Knowledge | OMC | 3 | 0 | 0 | 3 | Qualifying |
| 9. | 24B17BT311 | Summer Training II (6 weeks) | PRC | 0 | 0 | 0 | 0 | 2 |
| TOTAL | 24 | 21 | ||||||
| Sr. No. | Course Code | Course Title | Course Category | L | T | P | Total | Credits |
|---|---|---|---|---|---|---|---|---|
| 1. | 24B11BT312 | Biocomputing and Applications | PCC | 3 | 0 | 0 | 3 | 3 |
| 2. | 15B11BT511 | Cell Culture Technology | PCC | 3 | 0 | 0 | 3 | 3 |
| 3. | 24B11BT313 | Food and Agribiotechnology | PCC | 3 | 0 | 0 | 3 | 3 |
| 4. | XXXXXXX | Discipline Elective -4* | PEC | 3 | 0 | 0 | 3 | 3 |
| 5. | XXXXXXX | Discipline Elective -5* | PEC | 3 | 0 | 0 | 3 | 3 |
| 6. | XXXXXXX | Open Elective -1 | OEC | 2 | 0 | 0 | 2 | 2 |
| 7. | XXXXXXX | Selected Value Added Course | Value added | 2 | 0 | 0 | 2 | Audit |
| 8. | 15B17CI577 | IT Practice Lab | ESC | 0 | 0 | 2 | 2 | 1 |
| 9. | 15B17BT571 | Cell Culture Lab | PCC | 0 | 0 | 2 | 2 | 1 |
| 10. | 24B15HS311 | Soft Skill for Employability | HSC | 0 | 0 | 2 | 2 | 1 |
| 11. | 24B17BT311 | Minor Project | PRC | 0 | 0 | 4 | 4 | 2 |
| TOTAL | 29 | 22 | ||||||
| Sr. No. | Course Code | Course Title | Course Category | L | T | P | Total | Credits |
|---|---|---|---|---|---|---|---|---|
| 1. | XXXXXXX | Discipline Elective -6* | PEC | 3/2 | 0 | 0/2 | 3/4 | 3 |
| 2. | XXXXXXX | Open Elective -2 | OEC | 3 | 0 | 0 | 3 | 3 |
| 3. | 15B19EC791 | Major Project Part-1 | PRC | 0 | 0 | 8 | 8 | 4 |
| 4. | 24B17BT411 | Summer Training III (6 weeks) | PRC | 0 | 0 | 0 | 0 | 4 |
| TOTAL | 14 | 14 | ||||||
| Sr. No. | Course Code | Course Title | Course Category | L | T | P | Total | Credits |
|---|---|---|---|---|---|---|---|---|
| 1. | XXXXXXX | Discipline Elective -7* | PEC | 3/2 | 0 | 0/2 | 3/4 | 3 |
| 2. | XXXXXXX | Open Elective -3 | OEC | 3 | 0 | 0 | 3 | 3 |
| 3. | 24B17BT411 | Major Project Part-2 | PRC | 0 | 0 | 16 | 16 | 8 |
| TOTAL | 22 | 14 | ||||||
| Sr. No. | Course Code | Course Title | Course Category | L | T | P | Total | Credits |
|---|---|---|---|---|---|---|---|---|
| 1. | 24B17BT211 | Inter/Intra institutional activities (Training with higher Institutions, Soft skill training organized by Training and Placement Cell of the respective institutions; contribution at incubation/innovation entrepreneurship cell of the institute; participation in conferences/workshops/ competitions etc., Learning at Departmental Lab/Tinkering Lab/ Institutional workshop, Working for consultancy/research project within the institutes and Participation in all the activities of Institute's Innovation Council for eg. IPR workshop/ Leadership Talks/Idea/Design/Innovation/Business Completion/Technical Expos etc.) | PRC1 | 0 | 0 | 6 | 6 | 2 |
| TOTAL | 6 | 2 | ||||||
| Sr. No. | Course Code | Course Title | Course Category | L | T | P | Total | Credits |
|---|---|---|---|---|---|---|---|---|
| 1. | 24B17BT311 | Industrial/Govt./NGO/MSME/Rural Internship/ Innovation Entrepreneurship (Students may choose either to work on innovation or entrepreneurial activities resulting in start-up or undergo internship with industry/ NGO’s / Government organizations/ Micro/ Small/Medium enterprises to make themselves ready for the industry. In case student want to pursue their family business and don’t want to undergo internship, a declaration by a parent may be submitted directly to the TPO) | PRC1 | 0 | 0 | 6 | 6 | 2 |
| TOTAL | 6 | 2 | ||||||
| Sr. No. | Course Code | Course Title | Course Category | L | T | P | Total | Credits |
|---|---|---|---|---|---|---|---|---|
| 1. | 24B17BT411 | Industrial/Govt./NGO/MSME/Rural Internship/ Innovation/Entrepreneurship (Students may choose either to work on innovation or entrepreneurial activities resulting in start-up or undergo internship with industry/ NGO’s / Government organizations/ Micro/ Small/Medium enterprises to make themselves ready for the industry. In case student want to pursue their family business and don’t want to undergo internship, a declaration by a parent may be submitted directly to the TPO.) | PRC1 | 0 | 0 | 8 | 8 | 4 |
| TOTAL | 8 | 4 | ||||||


